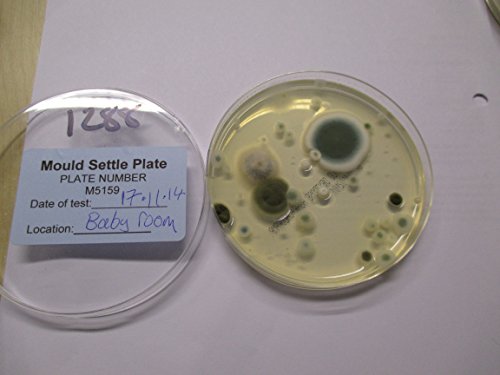

Description
- Simple to use test kit to check Mould levels in the air with a Written Report
- Contains a petri dish with agar specially to grow mould species
- Full instructions included with support - The plates are returned to us with a freepost label
- Once received we will incubate and report on the number of colonies and main species.
- We recommend that the kit is used within 5 days of receipt. All plates are prepared fresh for each order.
Worried about Mould in the Air? Have Asthma or Allergies? Think a room is damp? This test kit enables you to check the levels of mould in the air within a room. Easy to use with step by step instructions. Note these items are freshly prepared for each order so cannot be returned